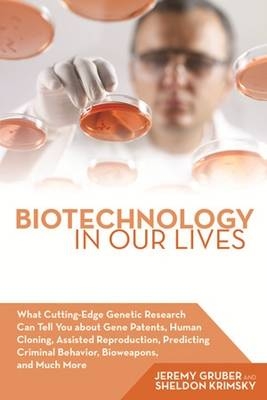
Charmers and Rogues

eBook Download (EPUB)
2015
|
Little, Brown Book Group
ISBN: 9780751560039
3,99 €
(CHF 3,90) (inkl. MwSt)
(CHF 3,90) (inkl. MwSt)
- Download sofort lieferbar